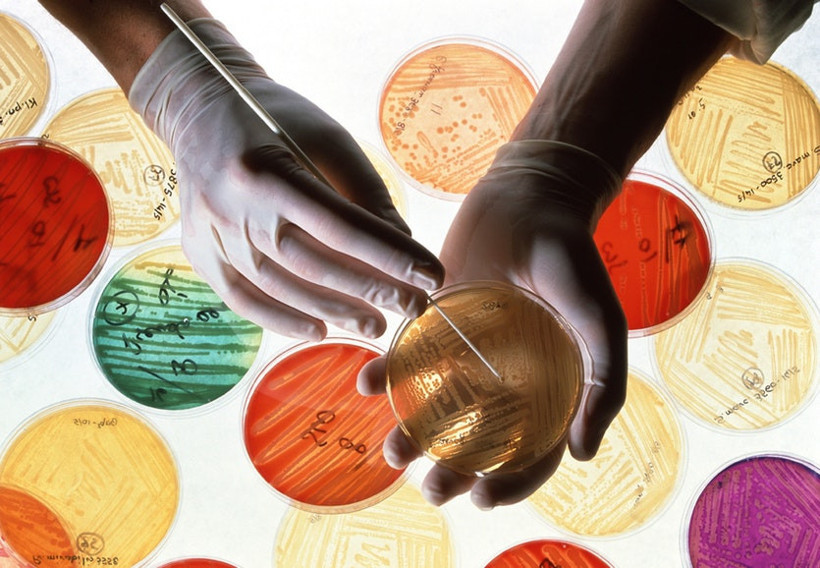
OECD açıkladı: Türkler büyük risk altında - Resim: 3

OECD açıkladı: Türkler büyük risk altında

Uluslararası Ekonomik İşbirliği ve Kalkınma Örgütü (OECD) Türkiye’nin antibiyotik direncinde ilk sırada olduğunu açıkladı. Kontrolsüz bir şekilde antibiyotik kullanılması bakterilerin antibiyotik ilaçlara yönelik dirençlerinin artmasına yol açtı.

Uluslararası Ekonomik İşbirliği ve Kalkınma Örgütü (OECD) Türkiye’nin antibiyotik direncinde ilk sırada olduğunu açıkladı.

Uluslararası Ekonomik İşbirliği ve Kalkınma Örgütü (OECD) antibiyotiklerin hasta kullanımları üzerindeki etkisini araştıran bir rapor yayınladı. OECD’nin yayınladığı raporda antibiyotiklerin hastalar üzerinde ne derece etkili olduğu ülkelere göre sıralandı. Yapılan araştırma sonucunda Türkiye’nin antibiyotik direnci konusunda ilk sırada olduğu öğrenildi. Antibiyotiklerin Türkiye’deki hastalar üzerinde en az etkili olduğunun ortaya çıktığı raporda Türkiye’yi sırası ile Yunanistan ve Güney Kore takip etti.
Bilim uzmanlarına göre, basit soğuk algınlıkları ya da grip tedavisinde bile antibiyotiklere başvurulması, geçmişte hayvan yemlerine kontrolsüz bir şekilde koruyucu olarak antibiyotik katılması gibi bilinçsiz kullanımlar, bakterilerin antibiyotik ilaçlara yönelik dirençlerinin artmasına yol açtı. Antibiyotik direncinin artması, doğrudan antibiyotiklerin etkisinin azalmasına da sebep oldu.

Antibiyotiklere dirençli bakterilerin artması yüzünden 2015 ve 2050 yılları arasında Avrupa, Kuzey Amerika ve Avustralya’da gerekli tedbirler alınmadığı takdirde 2.4 milyon kişinin hayatını kaybedeceği uyarısı yapılırken, kişi başına yılda 2 dolarlık bir yatırımla bu ölümlerin dörtte üçünün engellenebileceği belirtildi.